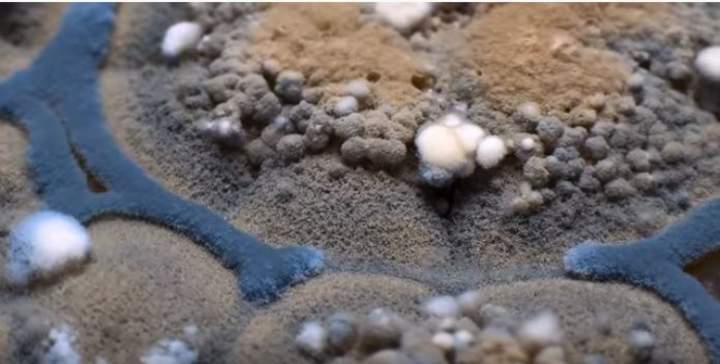
Imagen portada

Año publicación: 2019
Descargar recursos
Video
Enlace externo
Descripción
Hongos
Clasificaciones
Cursos / Niveles
7° Básico
Asignaturas / Ambitos
Ciencias Naturales
Eje
Biología
OA
Objetivo de aprendizaje CN07 OA 05